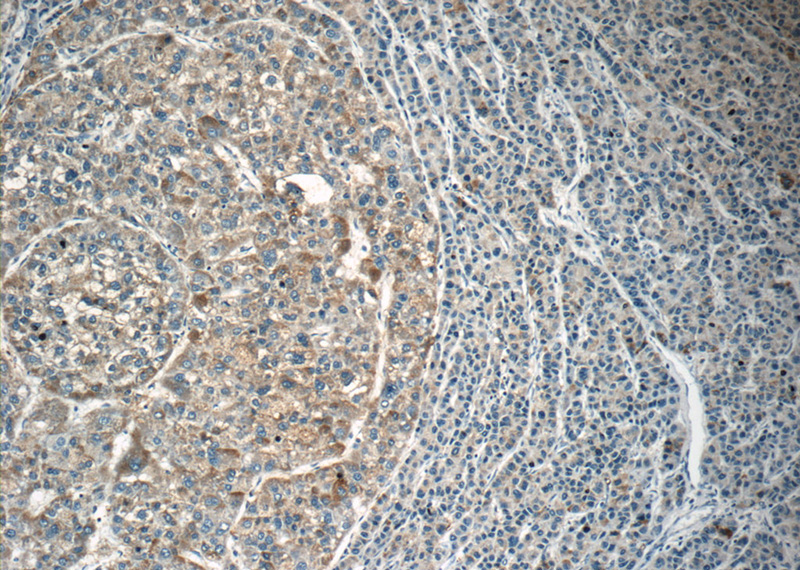
Immunohistochemistry of paraffin-embedded human liver cancer tissue slide using Catalog No:112143(LAPTM4B Antibody) at dilution of 1:50 (under 10x lens)
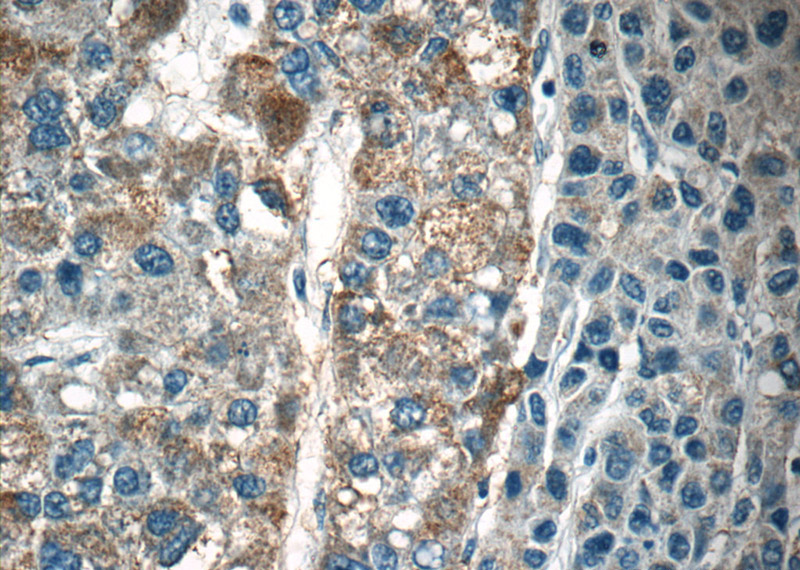
Immunohistochemistry of paraffin-embedded human liver cancer tissue slide using Catalog No:112143(LAPTM4B Antibody) at dilution of 1:50 (under 40x lens)

-
Product Name
LAPTM4B antibody
- Documents
-
Description
LAPTM4B Rabbit Polyclonal antibody. Positive IHC detected in human liver cancer tissue, human heart tissue. Positive WB detected in mouse lymph tissue, rat lymph tissue. Observed molecular weight by Western-blot: 24 kDa
-
Tested applications
ELISA, WB, IHC
-
Species reactivity
Human,Mouse,Rat; other species not tested.
-
Alternative names
LAPTM4B antibody; LAPTM4beta antibody; LC27 antibody
- Immunogen
-
Isotype
Rabbit IgG
-
Preparation
This antibody was obtained by immunization of LAPTM4B recombinant protein (Accession Number: NM_018407). Purification method: Antigen affinity purified.
-
Clonality
Polyclonal
-
Formulation
PBS with 0.02% sodium azide and 50% glycerol pH 7.3.
-
Storage instructions
Store at -20℃. DO NOT ALIQUOT
-
Applications
Recommended Dilution:
WB: 1:500-1:5000
IHC: 1:20-1:200
-
Validations

mouse lymph tissue were subjected to SDS PAGE followed by western blot with Catalog No:112143(LAPTM4B antibody) at dilution of 1:800
Immunohistochemistry of paraffin-embedded human liver cancer tissue slide using Catalog No:112143(LAPTM4B Antibody) at dilution of 1:50 (under 10x lens)
Immunohistochemistry of paraffin-embedded human liver cancer tissue slide using Catalog No:112143(LAPTM4B Antibody) at dilution of 1:50 (under 40x lens)
-
Background
LAPTM4B, a novel oncoprotein, is associated with the prognosis of cancer, and may play important roles in the initiation, promotion and metastasis of tumors. It was initially identified as a hepatocellular carcinoma-associated gene, and was recently shown to be up-regulated in various human cancers. Some studies indicated that LAPTM4B may be an useful marker of prognosis in ovarian carcinoma and endometrial cancer. LAPTM4B belongs to the LAPTM4/LAPTM5 transporter family. It has 3 isoforms with molecular masses 41kd, 35 kd and 24 kd. This antibody can recognize all the 3 isoforms of LAPTM4B.
-
References
- Tan X, Thapa N, Sun Y, Anderson RA. A kinase-independent role for EGF receptor in autophagy initiation. Cell. 160(1-2):145-60. 2015.
- Milkereit R, Persaud A, Vanoaica L, Guetg A, Verrey F, Rotin D. LAPTM4b recruits the LAT1-4F2hc Leu transporter to lysosomes and promotes mTORC1 activation. Nature communications. 6:7250. 2015.
Related Products / Services
Please note: All products are "FOR RESEARCH USE ONLY AND ARE NOT INTENDED FOR DIAGNOSTIC OR THERAPEUTIC USE"
